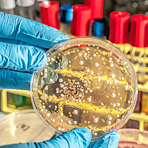

Ciprofloxacin: Erst wirken, dann zerfallen? |
Ein Ciprofloxacin, das gegen Bakterien wirkt, aber in der Umwelt schnell zerfällt? Der Arbeitsgruppe um Professor Klaus Kümmerer von der Leuphana Universität Lüneburg ist es gelungen, Antibiotika dieser Substanzklasse zu entwickeln, die durch natürliche Zerfallsprozesse in der Umwelt unwirksam werden.
Fünf Jahre lang arbeiteten die Forscher ausgehend von Ciprofloxacin an der Entwicklung eines Antibiotikums, das nach seiner medizinischen Verwendung zerfällt und nicht mehr aktiv ist. Die Leuphana habe die neuen Wirkstoffe zum Patent angemeldet, heißt es in einer Meldung der Universität. «Wir haben Wirkstoffe entwickelt, die im Reagenzglas funktionieren, aber noch kein fertiges Medikament», sagt Kümmerer. Das sei die Aufgabe von potenziellen Partnern in der Pharmaindustrie.
Das Breitband-Antibiotikum wurde ausgewählt, weil es sehr häufig verordnet wird und nach der Anwendung weitgehend unverändert in die Umwelt gelangt und dort weiterhin aktiv ist. Bereits kleine Konzentrationen fördern das Wachstum resistenter Krankheitserreger. Damit der neue Wirkstoff gezielt zerfällt, mussten chemische Bindungen raffiniert destabilisiert werden, sodass sie beispielsweise im Blut ausreichend stabil sind, nach der Passage durch den Körper aber zerfallen. «Benign by Design» heißt der Ansatz, bei dem neue Moleküle so konstruiert werden, dass sie umweltverträglicher sind.
Gefördert wird das Projekt seit 2014 von der Deutschen Bundesstiftung Umwelt mit etwa 460.000 Euro. 2015 gelang es den Wissenschaftlern von der Leuphana, die biologische Abbaubarkeit eines Betablockers zu verbessern. Sie erwarten, dass neue Moleküle auch neue Marktchancen eröffnen, vor allem wenn die Umweltverträglichkeit von Anfang an mit eingebaut wurde. (bmg)
Lesen Sie dazu auch
Forschung: Antibiotika sollen umweltfreundlicher werden
24.11.2017 l PZ
Foto: Fotolia/Photographee.eu